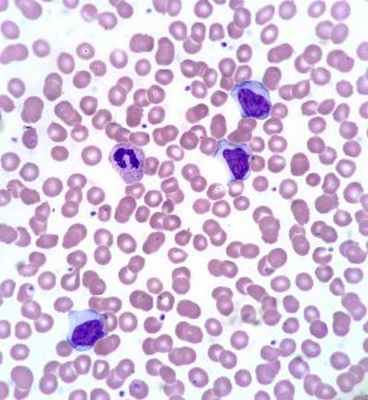

Инфекционный мононуклеоз
Добавил пользователь Евгений Кузнецов Обновлено: 23.11.2025
Инфекционный мононуклеоз – острое проявление вирусного заболевания, клинически затрагивающее ротовую область, глотку, селезенку, печень и лимфоузлы. Провокатор его возникновения – герпесвирус Эпштейна-Барра, встречающийся как у взрослых, так и среди детей.
Распространенность недуга не зависит от времени года или пола человека. Впрочем, исследователи выявили некоторую закономерность: у подростков, проходящих пубертатный период, болезнь определяется чаще.
Основные причины
Причина инфекционного мононуклеоза одна – вирус Эпштейна-Барра. Им можно заразиться после контакта с заболевшим человеком. Так как частицы вируса сохраняются в слюне носителя, то основной способ передачи его – воздушно-капельный.
Поймать вирус можно, воспользовавшись одними предметами обихода с зараженным носителем. Часто передача происходит половым путем, а также через поцелуи, невымытые руки, посуду и т.д.
В некоторых случаях вирус передается в момент переливания крови, а также от матери к малышу в период вынашивания.
Наиболее подвержены болезни люди с ослабленным иммунитетом, острой нехваткой полноценного сна и рационального питания.
Симптоматика недуга
Симптомы инфекционного мононуклеоза проявляются не сразу: инкубационный период может колебаться в промежутке от 5 до 45 дней. В некоторых случаях заболевший может отмечать у себя следующие первичные признаки:
- общее физическое недомогание;
- слабость в теле, упадок сил;
- легкую заложенность носа.
Постепенно проявления увеличивают свою интенсивность, к ним добавляются такие симптомы:
Спустя время заболевший замечает:
- сильную лихорадку;
- головную боль;
- ломоту в теле;
- острую боль в горле в момент глотания.
Если обратиться к врачу, то тот может обратить внимание на увеличение размеров селезенки и печени и симптомы фолликулярной, катаральной или язвенно-некротической ангины. К ним относятся увеличение миндалин, желтоватый налет на стенках глотки, возможна легкая кровоточивость.
Инфекционный мононуклеоз у детей по своим проявлениям схож с данным недугом у взрослых, отличаясь лишь повышенной скоростью развития.
После того, как печень и селезенка увеличиваются, они сразу дают сигнал об этом пожелтением глазных склер и кожи, а также более темным цветом мочи заболевшего. Могут наблюдаться кожные высыпания, сопровождающиеся легким зудом.
Возможные осложнения
Инфекционный мононуклеоз у взрослых и тем более детей игнорировать нельзя, так как он чреват осложнениями:
- сохраняясь в организме пациента, вирус периодически дает рецидив болезни;
- велика вероятность развития инфекции – стрептококковой или стафилококковой. Попадая в ослабленный организм, бактерии обеспечивают особенно агрессивное проявление;
- менингоэнцефалит – серьезное неврологическое заболевание, затрагивающее церебральное вещество головного мозга;
- увеличившиеся миндалины способны спровоцировать затруднение дыхания и обструкцию верхних дыхательных путей;
- в качестве осложнения инфекционного мононуклеоза у детей возможен гепатит, инфильтрация легких;
- тромбоцитопения – в крайне редких случаях.
Диагностика недуга

Диагностика инфекционного мононуклеоза весьма обширная. После осмотра пациента терапевт, инфекционист или педиатр (у детей) назначает сдачу общего анализа крови. В нем о наличии недуга говорит слабый лейкоцитоз и смещение формулы лейкоцитов в левую сторону.
В крови обнаруживаются атипичные мононуклеары. К слову, именно из-за них пациенту рекомендуется три раза с определенными промежутками времени проходить серологическое обследование, так как эти вещества характерны и для ВИЧ-инфекции.
Дополнительно сдается ПЦР для определения вируса Эпштейна-Барра и его активности в организме пациента. Могут быть дополнительно найдены М-иммуноглобулины.
При инфекционном мононуклеозе с характерными признаками ангины рекомендуется дополнительно осмотр отоларинголога.
Лечение заболевания
В зависимости от особенности протекания лечение инфекционного мононуклеоза может проходить в условиях стационара или дома. Больному полагается соблюдение постельного режима, а в некоторых случаях – еще и специальной диеты.
Комплекс лечения направлен на снятие интоксикации организма, симптомов, приведение его в стабильное состояние. Наряду с этим назначается витаминная терапия (качественное питание, витаминные комплексы по возрасту).
Тяжелые случаи инфекционного мононуклеоза с явно выраженными некротизирующими процессами требуют участия антибиотиков. В случае если имеет место разрыв селезенки, то в экстренном порядке осуществляется ее полное удаление.
Профилактические меры
Если заболевание проходит без серьезных осложнений и под наблюдением врача, прогноз благоприятный. После выздоровления в течение года рекомендуется несколько раз сдавать общий анализ крови и анализ на определение активности вируса Эпштейна-Барра.
К другим мерам профилактики инфекционного мононуклеоза относятся:
- рациональное закаливание;
- прием витаминных комплексов в осенне-зимний период;
- длительные прогулки на свежем воздухе;
- умеренная физическая активность;
- тщательная дезинфекция всех личных вещей и помещений, в которых находился заболевший.
Ответы на распространенные вопросы
Как не заболеть инфекционным мононуклеозом?
К сожалению, полностью оградить себя от этого заболевания невозможно. Однако можно предпринять профилактические меры, чтобы снизить риск осложнений. В период простудных заболеваний желательно избегать мест большого скопления людей.
Какие могут быть последствия этой болезни?
Последствия инфекционного мононуклеоза – это осложнения, с которыми сталкивается ослабленный организм или тот, который не получил должного лечения. К ним относятся дополнительная бактериальная инфекция, менингоэнцефалит, гепатит. В большинстве основное последствие заболевания – падением иммунитета.
Инфекционный мононуклеоз: чем лечить?
Лечение подбирается врачом в индивидуальном порядке. Важно снять симптомы и токсическую нагрузку на организм. При наличии бактериальной инфекции – использовать антибиотики.
Инфекционный мононуклеоз (болезнь Филатова, железистая лихорадка)
Информацию из данного раздела нельзя использовать для самодиагностики и самолечения. В случае боли или иного обострения заболевания диагностические исследования должен назначать только лечащий врач. Для постановки диагноза и правильного назначения лечения следует обращаться к Вашему лечащему врачу.
Инфекционный мононуклеоз: причины появления, симптомы, диагностика и способы лечения.
Определение
Инфекционный мононуклеоз – заболевание вирусной природы, при котором развивается лихорадка, увеличиваются печень и селезенка, лимфатические узлы, поражаются гортань, глотка. В крови регистрируются свойственные только этой патологии изменения (появление атипичных мононуклеаров, лимфоцитоз). В ряде случаев инфекционный мононуклеоз имеет хроническое течение, при некоторых состояниях клиническая картина стерта, что существенно затрудняет диагностику и постановку верного диагноза.
Причины появления инфекционного мононуклеоза
Заболевание вызывают вирусы семейства герпесвирусов, самым частым возбудителем считается вирус Эпштейна–Барр (ВЭБ, или вирус герпеса человека 4-го типа). Большинство людей переносят его в стертой клинической форме в детстве и юношестве, что подтверждается анализами крови на содержание иммуноглобулинов, которые вырабатываются в ответ на попадание вирусов в организм человека: по статистике у 9 из 10 взрослых положительные анализы крови на ДНК этого вируса.
Пути передачи вируса, вызывающего инфекционный мононуклеоз:
- Воздушно-капельный.
- Контактно-бытовой (в том числе половой).
- Парентеральный – во время переливания крови, пересадки органов и тканей в течение 6 предшествующих заболеванию месяцев.
К предрасполагающим факторам развития болезни относятся такие состояния, как снижение иммунитета, длительно текущие заболевания или обострение хронических патологий, неблагоприятная психоэмоциональная и экологическая обстановка.
Классификация заболевания
Единой общепринятой классификации инфекционного мононуклеоза нет. Для удобства формулировки диагноза используются следующие разделения патологии на группы:
По возбудителю:
- Вирус Эпштейна–Барр (ВЭБ).
- Цитомегаловирус.
- Вирус герпеса 6-го и 7-го типов (HV6, HV7).
- Аденовирус.
- Вирус иммунодефицита.
- Toxoplasma gondii (токсоплазма).
- Типичный – свойственная мононуклеозу клиническая картина и патогномоничные (характерные только для этого заболевания) изменения в анализах крови.
- Атипичный – стертая клиника, бессимптомное течение.
- Острый инфекционный мононуклеоз – проявления заболевания регистрируются в течение не более 3 месяцев.
- Затяжное течение (3–6 месяцев).
- Рецидивирующее течение – симптомы патологии возникают вновь через 1 месяц и менее после перенесенного заболевания.
- Хроническое – симптомы беспокоят более 6 месяцев.
Симптомы инфекционного мононуклеоза
После внедрения в организм вируса Эпштейна–Барр в течение месяца или полутора никаких симптомов не возникает, этот период называют инкубационным. Затем пациента начинают беспокоить слабость, повышенная утомляемость, чувство общего недомогания, свойственные любой вирусной инфекции. В течение полутора недель все эти симптомы постепенно уменьшаются. Затем на фоне, казалось бы, полного выздоровления возникают сильная боль в горле, высокая лихорадка, слабость, увеличение лимфатических узлов. Эти симптомы могут беспокоить несколько недель, а недомогание и слабость – более месяца. Клиническая картина (боль в горле при глотании, увеличение лимфатических узлов) практически идентична таковой при ангине. Для постановки диагноза «инфекционный мононуклеоз» назначают анализ крови, при котором выявляются изменения, свойственные только этой болезни. У 10% больных в этот период на теле появляется сыпь (ее наличие или отсутствие не несет никакого прогностического значения). Из-за увеличения печени и селезенки возможно ощущение дискомфорта в животе, в подреберных областях.

Диагностика инфекционного мононуклеоза
Врач в первую очередь собирает анамнез и проводит визуальный осмотр пациента. При осмотре обращают на себя внимание увеличенные группы лимфатических узлов (в тяжелых случаях не только шейной группы, но даже внутренние лимфатические узлы), гиперемия (краснота) зева, увеличение селезенки и печени, которое врач выявляет при пальпации и перкуссии живота.
Вирус Эпштейна–Барр поражает В-лимфоциты (разновидность лейкоцитов – белых кровяных телец, отвечающих за иммунитет, в частности, вырабатывающих антитела), в ответ в крови появляются клетки, характерные только для такого поражения и носящие название «атипичные мононуклеары», а общее количество лимфоцитов преобладает над количеством других лейкоцитов, возможно повышение или снижение общего количества белых кровяных телец, снижение гранулоцитов (подгруппы лейкоцитов, внутри которых есть специфические гранулы, где вырабатываются вещества для реализации иммунитета). К гранулоцитам относят, например, нейтрофилы, эозинофилы, базофилы. Все эти характерные для инфекционного мононуклеоза изменения выявляются при проведении клинического анализа крови.
Синонимы: Общий анализ крови, ОАК. Full blood count, FBC, Complete blood count (CBC) with differential white blood cell count (CBC with diff), Hemogram. Краткое описание исследования Клинический анализ крови: общий.
Мононуклеоз
Замучил хронический гайморит? Страдаете от постоянного насморка? Уже потеряли всякую надежду вздохнуть свободно? Воспалительные процессы в окол.
Скидки для друзей из социальных сетей!
Эта акция - для наших друзей в "Одноклассниках", "ВКонтакте", "Яндекс.Дзене", YouTube и Telegram! Если вы являетесь другом или подписчиком стр.
Для жителей районов Савеловский, Беговой, Аэропорт, Хорошевский
В этом месяце жителям районов Савеловский, Беговой, Аэропорт, Хорошевский» предоставляется скидка 5% на ВСЕ мед.
Второе мнение
Не уверены в правильности поставленного вам диагноза? Прочь сомнения! Приходите в «МедикСити» и бесплатно проконсультируйтесь у н.
Балашова Юлия Вячеславовна
Варнель Ольга Леонидовна
Высшая квалификационная категория, заведующая отделением оториноларингологии
Капустина Анна Александровна
Пономарева Лариса Викторовна
Высшая квалификационная категория
Пышный Дмитрий Владимирович
Высшая квалификационная категория, кандидат медицинских наук
Рамазанова Гюнай Альнияз-кызы
Кандидат медицинских наук
Мы в Telegram и "Одноклассниках"
Мононуклеоз – острое инфекционное заболевание, при котором поражается лимфатическая система. При моноуклеозе болит и воспаляется горло, больной постоянно утомлен, беспокоен, у него увеличена печень и лимфатические узлы. Мононуклеоз характеризуется увеличением моноцитов в циркулирующей крови.
Источник инфекции – инфицированный человек. Инфекция передается воздушно-капельно, чаще со слюной человека (при поцелуях), через переливание крови.
50% населения заболевают этой инфекцией в подростковом возрасте: девочки в 14-16 лет, мальчики в 16-18 лет. Люди старше 40 лет этой болезнью заражаются реже. Но у ВИЧ-инфицированных болезнь может наступить в любом возрасте.
Инфекционный мононуклеоз (еще эту болезнь называют железистой лихорадкой, моноцитарной ангиной) характеризуется лихорадкой, лимфаденопатией, тонзиллитом, увеличением размера печени и селезенки, может приобрести хронический характер. Возбудитель болезни – вирус Эпштейна-Барра, ВЭБ (группа вирусов герпеса).
Кроме увеличения размеров печени и селезенки, болезнь проявляется болями в животе, диспепсией, небольшими нарушениями функциональных способностей печени. В первые дни болезни происходят изменения в крови, лейкоцитоз, увеличение одноядерных клеток: лимфоцитов и моноцитов. Повышается СОЭ. Появляются атипичные клетки с одним ядром среднего и крупного размера – атипичные мононуклеары.



Симптомы мононуклеоза
Инфекционный мононуклеоз характеризуется поражением лимфоидной ткани носа, глотки, миндалин.
Другие симптомы болезни:
- увеличение подчелюстных, подмышечных, локтевых, паховых, заднешейных, трахеобронхиальных лимфоузлов;
- большое количество широкоплазменных моноуклеаров;
- лихорадка, увеличение лимфатических узлов, тонзиллит;
- боль в горле;
- затрудненное носовое дыхание;
- голос с носовым оттенком и др.
Болезнь сопровождается фолликулярной, лакунарной или катаральной ангиной, неприятным сладковато-приторным запахом изо рта.
Патогенез мононуклеоза
Вирус Эпштейна-Барра появляется в организме человека через слизистые носоглотки, затем распространяется по организму и накапливается в лимфоузлах. Вирус поддерживают В-лимфоциты, имеющие поверхностные рецепторы для вируса.
На самом пике болезни специфические вирусные антигены можно обнаружить у более чем 20% ядер В-лимфоцитов.
Когда инфекционный процесс пошел на убыль, вирусы мононуклеоза наблюдаются только в единичных В-лимфоцитах и эпителиальных тканях носоглотки. Когда часть пораженных клеток погибает, и освободившийся вирус поражает новые клетки, начинает неправильно работать клеточный и гуморальный иммунитет. Поэтому может образоваться супер-инфекция и наслоиться вторичная инфекция (чаще всего вызванная стафилококками или стрептококками).
При мононуклеозе вирус поражает лимфоидную и ретикулярную ткань, это приводит к увеличению лимфоузлов, также увеличиваются печень и селезенка.
Иммунитет при мононуклеозе стойкий. Инфекция может распространяться в виде бессимптомных и стертых форм, у 50-80% населения обнаружены антитела к этому вирусу.
Как протекает болезнь
Инкубационный период мононуклеоза - около недели. Заболевание начинается остро. 2-4 день характеризуются ярко выраженной лихорадкой и общей интоксикацией организма.
С первых дней человек чувствует слабость, головную боль, немного позже появляются боли при глотании. Температура поднимается до 38 - 40 градусов. На 5 день у больного может начаться тонзиллит. Он может быть катаральным, лакунарным или язвенно-некротическим. Поражаются лимфатические узлы. На теле может появиться сыпь, которая через 1-3 дня бесследно пропадает. Наблюдаются изменения в печени.
В периферической крови можно наблюдать лейкоцитоз. Число лимфоцитов, моноцитов и атипичных мононуклеаров достигает в первую неделю 80 -90%. После мононуклеоза мононуклеарная реакция может держаться от полугода до нескольких лет.
Возможны несколько вариантов исхода острого инфекционного процесса ВЭБ (мононуклеоза):
- выздоровление;
- бессимптомное вирусоносительство;
- хроническая рецидивирующая инфекция (хронический инфекционный мононуклеоз);
- развитие онкологического процесса (лимфомы, назофарингеальная карцинома, лейкоплакия языка и ротовой полости, рак желудка и кишечника);
- развитие аутоиммунного заболевания (ревматоидный артрит, системная красная волчанка).
Осложнения после болезни
Осложнения после инфекционного мононуклеоза бывают не очень часто, но довольно серьезные:
Инфекционный мононуклеоз: симптомы и лечение

Инфекционный мононуклеоз — это острое инфекционное заболевание, протекающее с высокой температурой, воспалением миндалин, увеличением лимфатических узлов, печени, селезёнки, и специфическим изменением в картине крови (появление в анализе мононуклеаров). Вызвано заболевание вирусом Эпштейна-Барра, который относится к семейству герпесвирусов.
Источником инфекции становится больной человек или носитель инфекции. Обычно мононуклеоз лечит врач-инфекционист, но очень часто такие пациенты впервые появляются именно у врача оториноларинголога, с жалобами на температуру и боль в горле.
Инфекционный мононуклеоз встречается повсеместно. Им болеют лица всех возрастных групп, но чаще это лица от 14 до 18 лет, реже дети раннего возраста и взрослые старше 40 лет.
Симптомы мононуклеоза
Чаще всего заболевание начинается с повышения температуры и сильной боли в горле, могут появляться налеты на миндалинах, сыпь на слизистой глотки в виде пузырьков, десна могут кровоточить. Постепенно увеличиваются в основном шейные, а текже подмышечные и паховые лимфатические узлы. Увеличение и воспаление шейных лимфоузлов и ангина - это наиболее частые и типичные признаки инфекционного мононуклеоза. Лимфоузлы болезненны, температура тела может достигать 40° и держаться постоянно или иметь волнообразный характер.
С первых дней заболевания увеличиваются печень и селезенка, иногда отмечаются боли в животе. Реже у больных возникает желтушность кожи и склер, сыпь.
Часто, на фоне приема антибиотиков пенициллинового ряда, по какой-то причине назначенных врачом, у больных появляется аллергическая сыпь.
Заболевание продолжается от 2-х до 4-х недель, иногда дольше. Постепенно исчезают лихорадка и налеты на миндалинах, нормализуется картина крови, размеры лимфатических узлов, селезенки и печени. Температура может держаться до 2-х недель, в отдельных случаях до месяца.
Диагностика инфекционного мононуклеоза
Диагностируется инфекционный мононуклеоз на основании нескольких анализов:
- анализ крови для выявления антител к вирусу Эпштейн-Барра;
- УЗИ брюшной полости для оценки состояния печени и селезенки;
- общий и биохимический анализ крови.
Иногда проводится диагностика для определения ВИЧ-инфекции, которая может проявляется как мононуклеоз.
Лечение мононуклеоза
Больных с лёгким и среднетяжёлым течением болезни лечат на дому. При более тяжелом течении необходимо стационарное лечение. Необходимость постельного режима определяется выраженностью интоксикации.
Лечение мононуклеоза симптоматическое. Используются противовирусные, жаропонижающие, противовоспалительные препараты. На стадии выздоровления средства для повышения иммунитета. Местно применяют антисептические средства, обезболивающие спреи для обеззараживания и облегчения состояния пациента. Допускается использование растворов для полоскания зева. Если нет аллергии на продукты пчеловодства, применяют мед. Это средство укрепляет иммунитет, смягчает горло и борется с бактериями.
Инфекционный мононуклеоз часто осложняется бактериальной инфекцией - в таком случае назначаются антибактериальные препараты, избегая пенициллиновую группу антибиотиков.
Пациентам назначают специальную диету, которую необходимо соблюдать в течение полугода. Не разрешается ничего жирного, копченого, сладкого, горох, фасоль.
После выздоровления необходимо наблюдение инфекционистом на протяжении 6 месяцев. Перенесенное заболевание оставляет после себя стойкий иммунитет.
В условиях «ЛОР клиники плюс 1» высококвалифицированные специалисты оториноларингологи проведут полный осмотр лор-органов с помощью эндоскопической техники. Назначат адекватное лечение, проведут диагностические мероприятия для постановки верного диагноза и при необходимости направят к другим профильным специалистам.
Инфекционный мононуклеоз
Инфекционный мононуклеоз – это острая антропонозная инфекция, вызываемая вирусом Эпштейна-Барра. Она характеризуется поражением лимфоидной ткани рото- и носоглотки, развитием лихорадочного состояния, лимфоаденопатией и гепатоспленомегалией, а также появлением в периферической крови атипичных мононуклеаров и гетерофильных антител.
Причины
Возбудителем инфекции является малоконтагиозныйлимфотропный вирус Эпштейна-Барра (ВЭБ), относящийся к семейству герпетических вирусов. Он обладает оппортуническими и онкогенными свойствами, содержит 2 молекулы ДНК и способен так же, как и другие возбудители данной группы пожизненно персистировать в человеческом организме, выделяясь из ротоглотки во внешнюю среду на протяжении 18 месяцев после первичного инфицирования. У подавляющего большинства взрослых людей выявляются гетерофильные антитела к ВЭБ, что подтверждает хроническое инфицирование данным возбудителем.
Вирус проникает в организм вместе со слюной (именно поэтому в некоторых источниках инфекционный мононуклеоз называется «болезнью поцелуев»). Первичным местом самовоспроизведения вирусных частиц в организме хозяина является ротоглотка. После поражения лимфоидной ткани возбудитель внедряется в В-лимфоциты (главная функция этих кровяных клеток — выработка антител). Оказывая прямое и опосредованное влияние на иммунные реакции, примерно через сутки после внедрения антигены вируса обнаруживаются непосредственно в ядре инфицированной клетки. При острой форме заболевания специфические вирусные антигены обнаруживаются приблизительно в 20% В-лимфоцитов, циркулирующих в периферической крови. Обладая пролиферативным действием, вирус Эпштейна-Барра способствует активному размножению В-лимфоцитов, в свою очередь, стимулирующих интенсивный иммунный ответ со стороны CD8+ и CD3+ Т-лимфоцитов.
Источниками инфекции являются вирусоносители, а также больные с типичными (манифестными) и стертыми (бессимптомными) формами заболевания. Вирус передается воздушно-капельным путем или посредством инфицированной слюны. В редких случаях возможно вертикальное заражение (от матери к плоду), инфицирование во время трансфузии и при половых контактах. Также существует предположение, что ВЭБ может передаваться через предметы домашнего обихода и алиментарным (водно-пищевым) путем.
Симптомы острого инфекционного мононуклеоза

В среднем длительность инкубационного периода составляет 7-10 дней (по сведениям различных авторов, от 5 до 50 дней).
В продромальном периоде пациенты жалуются на слабость, тошноту, быструю утомляемость, боли в горле. Постепенно негативные симптомы усиливаются, поднимается температура тела, появляются признаки ангины, затрудняется носовое дыхание, припухают шейные лимфатические узлы. Как правило, к концу первой недели острого периода болезни отмечается увеличение печени, селезенки и лимфоузлов на задней поверхности шеи, а также возникновение в периферической крови атипичных мононуклеаров.
У 3-15% больных инфекционным мононуклеозом наблюдается пастозность (припухлость) век, отек шейной клетчатки и кожные высыпания (пятнисто-папулезная сыпь).

Одним из наиболее характерных симптомов заболевания является поражение ротоглотки. Развитие воспалительного процесса сопровождается увеличением и отечностью небных и носоглоточной миндалин. Как следствие, затрудняется носовое дыхание, отмечается изменение тембра (сдавленность) голоса, больной дышит полуоткрытым ртом, издавая характерные «храпящие» звуки. Следует отметить, что при инфекционном мононуклеозе, не взирая на выраженную заложенность носа, в остром периоде заболевания не наблюдаются признаков ринореи (постоянных выделений носовой слизи). Такое состояние объясняется тем, что при развитии заболевания происходит поражение слизистой оболочки нижней носовой раковины (задний ринит). Вместе с тем для патологического состояния характерна отечность и гиперемия задней стенки глотки и наличие густой слизи.
У большинства инфицированных детей (порядка 85%) небные и носоглоточные миндалины покрываются налетами. В первые дни заболевания они сплошные, а затем приобретают вид полосок или островков. Возникновение налетов сопровождается ухудшением общего состояния и повышением температуры тела до 39-40°С.Увеличение печени и селезенки (гепатоспленомегалия) – еще один характерный симптом, наблюдающийся в 97-98% случаев инфекционного мононуклеоза. Размеры печени начинают изменяться с самых первых дней заболевания, достигая максимальных показателей на 4-10 сутки. Также возможно развитие умеренной желтушности кожи и пожелтение склер. Как правило, желтуха развивается в разгар заболевания и постепенно исчезает вместе с другими клиническими проявлениями. К концу первого, началу второго месяца размеры печени полностью нормализуются, реже орган остается увеличенным на протяжении трех месяцев.
Селезенка, так же, как и печень, достигает своих максимальных размеров на 4-10 день болезни. К концу третьей недели у половины пациентов она уже не пальпируется.
Сыпь, появляющаяся в разгар заболевания, может быть уртикарной, геморрагической, кореподобной и скарлатинозной. Иногда на границе твердого и мягкого неба появляются петихиальныеэкзантемы (точечные кровоизлияния). Фото сыпи при инфекционном мононуклеозе вы видите справа.
Со стороны сердечно-сосудистой системы не наблюдается серьезных изменений. Возможно возникновение систолического шума, приглушенность сердечных тонов и тахикардия. По мере стихания воспалительного процесса негативные симптомы, как правило, исчезают.
Чаще всего все признаки заболевания проходят через 2-4 недели (иногда через 1,5 недели). В то же время нормализация размеров увеличенных органов может задержаться на 1,5-2 месяца. Также на протяжении длительного времени возможно обнаружение в общем анализе крови атипичных мононуклеаров.
В детском возрасте хронического или рецидивирующегомононуклеоза не бывает. Прогноз благоприятный.
Осложнения
- Отек слизистой оболочки глотки и миндалин, приводящий к закупорке верхних дыхательных путей;
- Разрыв селезенки;
- Менингит с преобладанием в ликворе одноядерных клеток;
- Параличи;
- Поперечный миелит;
- Острый вялый паралич с белково-клеточной диссоциацией в ликворе (синдром Гийена-Баре);
- Психосенсорные расстройства;
- Интерстициальная пневмония;
- Гепатит;
- Миокардит;
- Гемолитическая и апластическая анемия;
- Тромбоцитопеническая пурпура.
С какими заболеваниями можно спутать?
Инфекционный мононуклеоз следует дифференцировать с:
- ОРВИ аденовирусной этиологии с выраженным мононуклеарным синдромом;
- дифтерией ротоглотки;
- вирусным гепатитом (желтушной формой);
- острым лейкозом.
Лечение инфекционного мононуклеоза
Лечение пациентов с легкими и среднетяжелыми формами заболевания может проводиться на дому (больной должен быть изолирован). В более тяжелых случаях требуется госпитализация в стационар. При назначении постельного режима учитывается степень выраженности интоксикации. В том случае, если инфекционный мононуклеоз протекает на фоне воспаления печени, рекомендуется лечебная диета (стол №5).
На сегодняшний день специфического лечения заболевания не существует. Пациентам проводится симптоматическая терапия, назначается десенсибилизирующее, дезинтоксикационное и общеукрепляющее лечение. При отсутствии бактериальных осложнений прием антибиотиков противопоказан. В обязательном порядке следует выполнять полоскание ротоглотки антисептическими растворами. При гипертоксическом течении и при наличии признаков асфиксии, возникшей вследствие выраженного увеличения миндалин и отека ротоглотки, показан короткий курс лечения глюкокортикоидами.
При лечении затяжных и хронических форм инфекционного мононуклеоза используются иммунокорректоры (препараты, восстанавливающие функцию иммунной системы).
Специфической профилактики заболевания на сегодняшний день не разработано.
Режим работы
c 8:00 до 20:00 — будние дни
с 8:00 до 14:00 — суббота
с 8:00 до 14:00 — воскресенье, прием ведут дежурные врачи
c 8:00 до 20:00 — будние дни женская консультация
Номер регистратуры
Регистратура поликлиники
8 (863) 236-35-20, 236-19-22
Регистратура женской консультации (Мадояна, 32)
(863)236-22-28
Регистратура женской консультации (Портовая, 97А)
(863)236-22-31
Читайте также:
